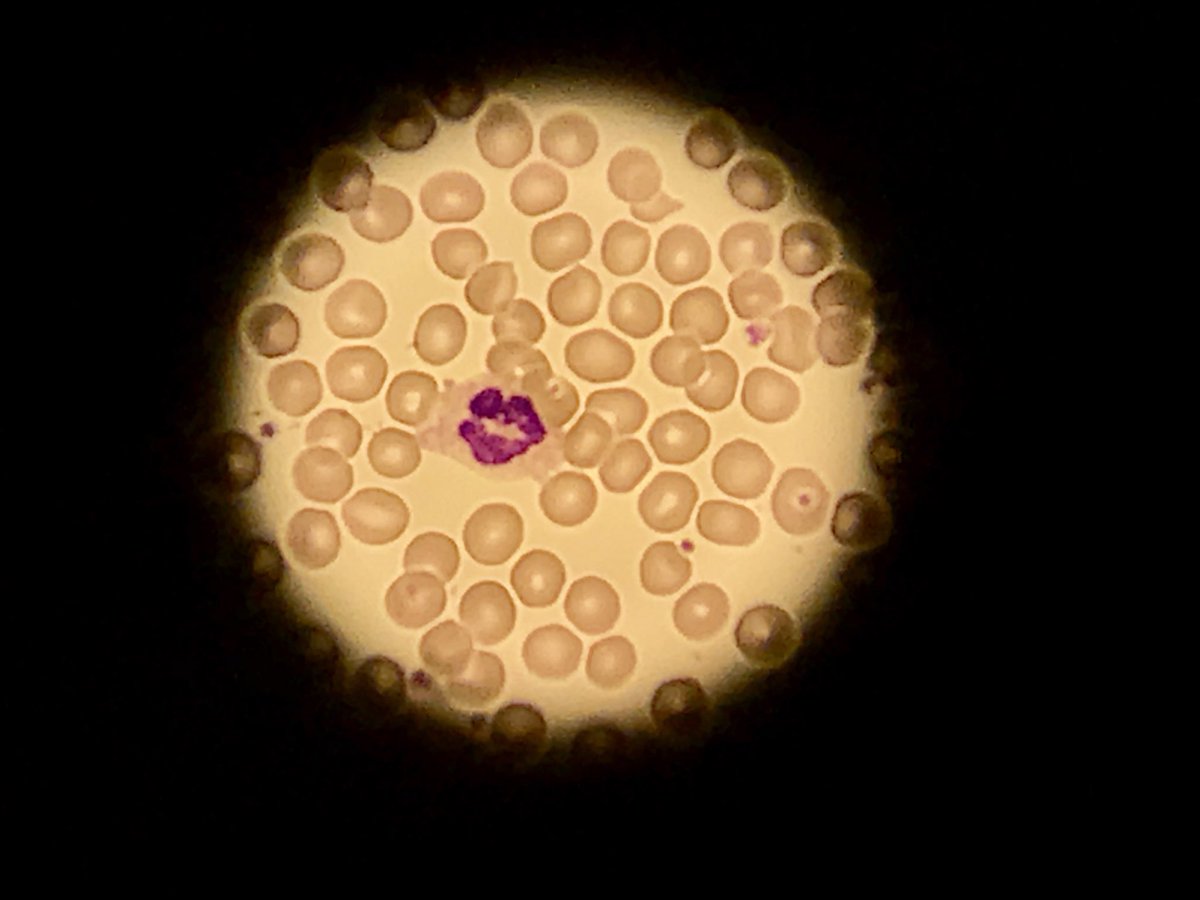
orr66's tweet image. “Ae fond kiss” # chance finding of a wee neutrophil down the microscope today # mwah

johanna orr
@orr66
specialist biomedical scientist in haematology & blood transfusion @ Rah paisley
You might like
We’d like to give a huge shout out to the thousands and thousands of scientific and laboratory staff across the NHS. Many of them have felt invisible during the pandemic, but we want them all to know that their vital role is recognised and so appreciated.

While many of us are home sipping on coffee/tea, complaining we are stuck in our homes and its the governments fault. Remember there are thousands of lab professionals working all weekend to process thousands of tests. Take a better look. Our lives are not that bad. #medlabthx
The impact of biomedical science on my own healthcare led me into the field. Proud to be a BMS 💉❤️
“Ae fond kiss” # chance finding of a wee neutrophil down the microscope today # mwah
Did you know? Lightly powder lashes to give mascara a coat to cling to. Lashes will appear fuller.
To fix puffy eyes or dark circles: Brew two green tea bags, and let them cool. Then lie down and place them over your eyes for 10 minutes.
Christmas was illegal in the U.S. until 1836 as it was considered an Ancient Pagan Holiday.
One of the hardest tasks for the human mind is convincing yourself that you no longer care.
Twerking is actually good exercise. It works the deep muscles of the hips, as well as the core muscles of the lower back and abs.
The face, neck and hands all show the signs of aging first! Pay special attention to these parts when moisturizing.
Don't shake polish. Otherwise, you may cause tiny bubbles to form, which can lead to chipping. Roll the bottle between your palms instead
The brain naturally craves 4 things: Food, Sex, Water and Sleep.
The first person you think of in the morning or last person you think of in the night is either the cause of your happiness or your pain.
United States Trends
- 1. Browns 30,1 B posts
- 2. Steelers 31 B posts
- 3. #HereWeGo 3.262 posts
- 4. Diggs 6.313 posts
- 5. #DawgPound 2.782 posts
- 6. Tomlin 3.270 posts
- 7. #KeepPounding 1.601 posts
- 8. Dugger N/A
- 9. Shedeur Sanders 6.232 posts
- 10. Harold Fannin 1.585 posts
- 11. Chuck Clark N/A
- 12. Brady Cook N/A
- 13. Brigitte Bardot 235 B posts
- 14. Go Birds 6.371 posts
- 15. Ja'Marr Chase 1.867 posts
- 16. #PITvsCLE N/A
- 17. Theo Wease N/A
- 18. #AskFFT N/A
- 19. Quinn Ewers 1.040 posts
- 20. Perine N/A
You might like
Something went wrong.
Something went wrong.



























































































